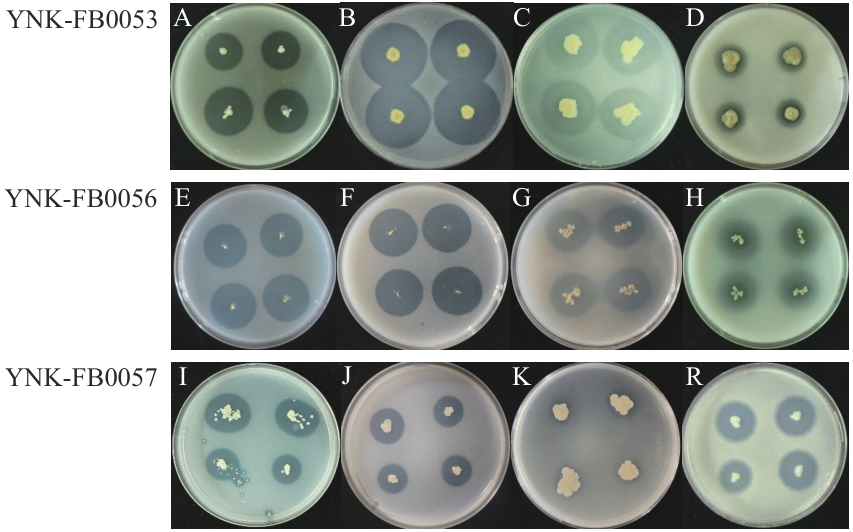
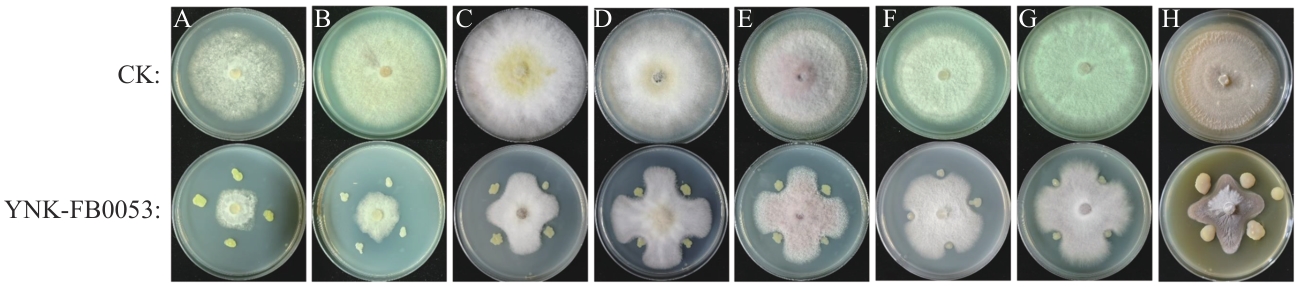

生物技术通报 ›› 2026, Vol. 42 ›› Issue (1): 315-328.doi: 10.13560/j.cnki.biotech.bull.1985.2025-0731
陈艳1( ), 刘鑫2, 施竹凤2, 普特2, 刘恩德1, 张义杰2, 曹艳茹1(
), 刘鑫2, 施竹凤2, 普特2, 刘恩德1, 张义杰2, 曹艳茹1( ), 杨佩文2(
), 杨佩文2( )
)
收稿日期:2025-07-07
出版日期:2026-01-26
发布日期:2026-02-04
通讯作者:
曹艳茹,女,博士,教授,研究方向 :微生物资源发掘与利用;E-mail: yanrucao3@aliyun.com作者简介:陈艳,女,硕士研究生,研究方向 :微生物资源发掘与利用;E-mail: 1561761657@qq.com
基金资助:
CHEN Yan1( ), LIU Xin2, SHI Zhu-feng2, PU Te2, LIU En-de1, ZHANG Yi-jie2, CAO Yan-ru1(
), LIU Xin2, SHI Zhu-feng2, PU Te2, LIU En-de1, ZHANG Yi-jie2, CAO Yan-ru1( ), YANG Pei-wen2(
), YANG Pei-wen2( )
)
Received:2025-07-07
Published:2026-01-26
Online:2026-02-04
摘要:
目的 针对农业土壤硫有效性低、作物缺硫的问题,从云南油菜根际土壤中筛选兼具高效硫氧化能力与多种生物活性的硫氧化细菌(sulfur-oxidizing bacteria, SOB),明确其农业应用潜力。 方法 采用定向富集分离法,通过pH降低和硫酸盐生成量评估硫氧化活性,结合固氮、溶锌、磷酸盐溶解等功能测定筛选多功能菌株;进一步测定活性菌株分泌铁载体、吲哚乙酸和拮抗病原菌等生物活性,并验证促种子发芽和番茄植株生长效果。 结果 分离获得313株SOB,其中16株具有较强的硫氧化能力(硫酸盐产量38.53-66.54 mg/L);结合形态学、生理生化特性和16S rDNA序列测序,3株高活性菌株YNK-FB0053、YNK-FB0056和YNK-FB0057分别鉴定为唐菖蒲伯克霍尔德氏菌(Burkholderia gladioli)、泛菌(Pantoea endophytica)和阿氏芽胞杆菌(Priestia aryabhattai);3个菌株兼具固氮、溶锌、磷酸盐溶解和分泌铁载体活性并携带srfAB、yndJ、ituC、sboA、bioA、NRPS和PKSI等抗生素基因;种子萌发试验显示,3株菌对油菜、番茄、黑麦萌发率提升16.67%-44.33%,整株长增加17.95%-33.70%;番茄盆栽试验中,3株菌均显著(P<0.05)促进生长,其中叶绿素含量、株高和茎粗提高约15%-30%,根长增加超过55%,地下部生物量增幅最为显著。养分积累方面,全氮、全磷、全钾和全硫均有所提升,其中铁元素含量增加最为明显,提升了112.50%。 结论 云南油菜根际土壤富含兼具高效硫氧化与多种生物活性的SOB,YNK-FB0053、YNK-FB0056和YNK-FB0057可显著促进种子萌发、番茄生长及植株元素吸收,具有良好的农业应用潜力。
陈艳, 刘鑫, 施竹凤, 普特, 刘恩德, 张义杰, 曹艳茹, 杨佩文. 三株硫氧化细菌的筛选鉴定及其生物活性[J]. 生物技术通报, 2026, 42(1): 315-328.
CHEN Yan, LIU Xin, SHI Zhu-feng, PU Te, LIU En-de, ZHANG Yi-jie, CAO Yan-ru, YANG Pei-wen. Screening, Identification and Biological Activity of Three Sulfur-oxidizing Bacteria[J]. Biotechnology Bulletin, 2026, 42(1): 315-328.
| 序号 No. | 州(市) Prefectures (Cities) | 海拔 Height (m) | 经度(E) Longitude | 纬度(N) Latitude |
|---|---|---|---|---|
| 1 | 丽江 | 1 832 | 105°17′09″ | 27°51′27″ |
| 2 | 大理 | 1 969 | 100°08′28.77″ | 25°37′1.82″ |
| 3 | 曲靖 | 1 590 | 104°23′38.07″ | 25°21′39.99″ |
| 4 | 保山 | 1 650 | 98°32′31″ | 24°56′48.93″ |
| 5 | 楚雄 | 1 816 | 101°37′01.35″ | 25°18′33.10″ |
| 6 | 昭通 | 2 141 | 105°17′09″ | 27°51′27″ |
| 7 | 迪庆 | 3 122 | 98°39′11.83″ | 27°58′6.77″ |
| 8 | 怒江 | 2 963 | 99°51′35.64″ | 27°10′58.80″ |
表1 土壤采样点
Table 1 Soil sampling location
| 序号 No. | 州(市) Prefectures (Cities) | 海拔 Height (m) | 经度(E) Longitude | 纬度(N) Latitude |
|---|---|---|---|---|
| 1 | 丽江 | 1 832 | 105°17′09″ | 27°51′27″ |
| 2 | 大理 | 1 969 | 100°08′28.77″ | 25°37′1.82″ |
| 3 | 曲靖 | 1 590 | 104°23′38.07″ | 25°21′39.99″ |
| 4 | 保山 | 1 650 | 98°32′31″ | 24°56′48.93″ |
| 5 | 楚雄 | 1 816 | 101°37′01.35″ | 25°18′33.10″ |
| 6 | 昭通 | 2 141 | 105°17′09″ | 27°51′27″ |
| 7 | 迪庆 | 3 122 | 98°39′11.83″ | 27°58′6.77″ |
| 8 | 怒江 | 2 963 | 99°51′35.64″ | 27°10′58.80″ |
| 引物名称Primer name | 引物序列Primer sequence (5′-3′) | 产物长度Product length (bp) | 参考文献Reference |
|---|---|---|---|
| SrfAB | GTTCTCGCAGTCCAGCAGAAG GCCGAGCGTATCCGTACCGAG | 308 | [ |
| yndJ | CAGAGCGACAGCAATCACAT TGAATTTCGGTCCGCTTATC | 212 | [ |
| fenD | CCTGCAGAAGGAGAAGTGAAG TGCTCATCGTCTTCCGTTTC | 293 | [ |
| ituC | TTCACTTTTGATCTGGCGAT CGTCCGGTACATTTTCAC | 575 | [ |
| bamC | CTGGAAGAGATGCCGCTTAC AAGAGTGCGTTTTCTTCGGA | 957 | [ |
| dhbC | ATGTTGGATCAAAACGTTAT TCATATGTGATCCACGCCCA | 1 197 | [ |
| sboA | TCGGTTTGTAAACTTCAACTGC GTCCACTAGACAAGCGGCTC | 334 | [ |
| ysnE | GGCTGTGAACCTTTGCTATG GCTGTTCGGGTCCTCTTTAT | 462 | [ |
| bioA | TTCCACGGCCATTCCTATAC TTTGTCCCCTTATCCTGCAC | 210 | [ |
| PKSI | TSAAGTCSAACATCGGB CGCAGGTTSCSGTACCAG | 1 200—1 400 | [ |
| PKSII | ACCGGCT GCACSTCSGGSCT ACGTAGTCSAGGTCGCASAC | 700 | [ |
| NRPS | GCSTACSYSATSTACACSTCSGG SASGTCVCCSGTSCGGTAS | 800 | [ |
表2 抗生素基因检测引物
Table 2 Primers for antibiotic gene detection
| 引物名称Primer name | 引物序列Primer sequence (5′-3′) | 产物长度Product length (bp) | 参考文献Reference |
|---|---|---|---|
| SrfAB | GTTCTCGCAGTCCAGCAGAAG GCCGAGCGTATCCGTACCGAG | 308 | [ |
| yndJ | CAGAGCGACAGCAATCACAT TGAATTTCGGTCCGCTTATC | 212 | [ |
| fenD | CCTGCAGAAGGAGAAGTGAAG TGCTCATCGTCTTCCGTTTC | 293 | [ |
| ituC | TTCACTTTTGATCTGGCGAT CGTCCGGTACATTTTCAC | 575 | [ |
| bamC | CTGGAAGAGATGCCGCTTAC AAGAGTGCGTTTTCTTCGGA | 957 | [ |
| dhbC | ATGTTGGATCAAAACGTTAT TCATATGTGATCCACGCCCA | 1 197 | [ |
| sboA | TCGGTTTGTAAACTTCAACTGC GTCCACTAGACAAGCGGCTC | 334 | [ |
| ysnE | GGCTGTGAACCTTTGCTATG GCTGTTCGGGTCCTCTTTAT | 462 | [ |
| bioA | TTCCACGGCCATTCCTATAC TTTGTCCCCTTATCCTGCAC | 210 | [ |
| PKSI | TSAAGTCSAACATCGGB CGCAGGTTSCSGTACCAG | 1 200—1 400 | [ |
| PKSII | ACCGGCT GCACSTCSGGSCT ACGTAGTCSAGGTCGCASAC | 700 | [ |
| NRPS | GCSTACSYSATSTACACSTCSGG SASGTCVCCSGTSCGGTAS | 800 | [ |
图1 菌株的营养转化效果图菌株YNK-FB0053的固氮(A)、溶锌(B)、解磷(C)、溶磷(D)效果;YNK-FB0056的固氮(E)、溶锌(F)、解磷(G)、溶磷(H)效果;YNK-FB0057的固氮(I)、溶锌(J)、解磷(K)、溶磷(R)效果
Fig. 1 Nutrient transformation effect diagrams of strainsEffect diagram of nitrogen fixation(A), zinc dissolution(B), phosphorus solution(C), dissolved phosphorus(D) of YNK-FB0053; nitrogen fixation(E), zinc dissolution(F), phosphorus solution(G), dissolved phosphorus(H) of YNK-FB0056; nitrogen fixation(I), zinc dissolution(J), phosphorus solution(K), dissolved phosphorus(R) of YNK-FB0057
| D/d | 固氮指数 Nitrogen fixation | 溶锌指数 Zinc dissolution | 解磷指数 Phosphorus solution | 溶磷指数 Phosphorus dissolution |
|---|---|---|---|---|
| YNK-FB0053 | 4.106±0.694a | 5.129± 0.459a | 3.453±0.320a | 1.506±0.425b |
| YNK-FB0056 | 4.476±0.240a | 5.087± 0.302a | 3.687±0.251a | 3.460±0.441a |
| YNK-FB0057 | 2.060±0.183b | 2.660±0.613b | 1.157±0.562b | 2.910±0.571ab |
表3 菌株的营养转化指数
Table 3 Nutrient transformation indexes of the strain
| D/d | 固氮指数 Nitrogen fixation | 溶锌指数 Zinc dissolution | 解磷指数 Phosphorus solution | 溶磷指数 Phosphorus dissolution |
|---|---|---|---|---|
| YNK-FB0053 | 4.106±0.694a | 5.129± 0.459a | 3.453±0.320a | 1.506±0.425b |
| YNK-FB0056 | 4.476±0.240a | 5.087± 0.302a | 3.687±0.251a | 3.460±0.441a |
| YNK-FB0057 | 2.060±0.183b | 2.660±0.613b | 1.157±0.562b | 2.910±0.571ab |
图5 菌株对病原菌的拮抗效果菌株YNK-FB0053对烟草疫霉菌(A)、轮纹镰刀菌(B)、腐皮镰刀菌(C)、木贼镰刀菌(D)、锐顶镰刀菌(E)、尖孢镰刀菌(F)和禾谷镰刀菌(G)的拮抗效果
Fig. 5 Antagonistic effects of strains on pathogenic bacteriaAntagonistic effect of strain YNK-FB0053 on Phytophthora nicotiana (A), F. concentricum (B),F. solani (C),F. equiseti (D),F. acuminatum (E), F. oxysporum (F), and F. graminearum (G)

图6 硫氧化细菌YNK-FB0053(A)、YNK-FB0056(B)和YNK-FB0057(C)抗生素合成基因PCR的检测结果
Fig. 6 PCR detection results of antibiotic synthesis genes in sulfur-oxidizing bacteria strains YNK-FB0053(A), YNK-FB0056(B), and YNK-FB0057(C)

图7 菌株处理后的种子萌发效果菌株YNK-FB0053、YNK-FB0056和YNK-FB0057对油菜(A)、番茄(B)和黑麦(C)处理的种子苗
Fig. 7 Germination effect of strain-treated seedsStrain YNK-FB0053, YNK-FB0056 and YNK-FB0057 treated seedlings of Brassica napus L (A), Solanum lycopersicum (B), and Secale cereale (C)

图8 菌株YNK-FB0053(A)、YNK-FB0056(B)和YNK-FB0057(C)处理下种子发芽长度和发芽率
Fig. 8 Germination lengths and germination rates of seeds of strain YNK-FB0053(A), YNK-FB0056(B) and YNK-FB0057(C)
处理 Treatment | 全氮 Total nitrogen (g/kg) | 全磷 Total phosphorus (g/kg) | 全钾 Total potassium (g/kg) | 全硫 Total sulfur (g/kg) | 全铁 Total iron (g/kg) | |
|---|---|---|---|---|---|---|
| CK1 | 37.33±0.99b | 8.20±0.28c | 60.27±1.69de | 11.26±0.22c | 0.48±0.04e | |
| CK2 | 35.90±1.47b | 7.80±0.38c | 58.47±3.27ef | 10.71±0.31de | 0.50±0.05e | |
| YNK-FB0053 | T1 | 35.90±0.62b | 9.20±0.29b | 63.50±1.90cd | 12.26±0.21b | 0.83±0.03b |
| T2 | 33.07±1.72c | 8.75±0.35b | 67.37±1.81b | 11.99±0.52b | 0.88±0.04b | |
| T3 | 35.17±0.64b | 9.79±0.09a | 73.43±0.83a | 13.34±0.20a | 0.78 ±0.01c | |
| YNK-FB0056 | T1 | 41.37±0.91a | 9.11±0.65b | 63.27±2.45cd | 11.32±0.16c | 0.73±0.10cd |
| T2 | 30.53±0.06d | 9.05±0.14b | 55.00±0.82f | 11.12±0.13cd | 0.77±0.02c | |
| T3 | 27.33±1.18e | 8.82±0.15b | 64.80±1.05bc | 11.47±0.16c | 0.70±0.03d | |
| YNK-FB0057 | T1 | 35.37±1.19b | 8.83±0.17b | 62.77±0.81cd | 10.45±0.33e | 0.84±0.03b |
| T2 | 42.40±1.35a | 8.96 ±0.21b | 66.63±1.56bc | 10.78±0.08de | 1.02±0.04a | |
| T3 | 26.27±1.81e | 9.83 ±0.16a | 64.80±3.77bc | 11.43±0.33c | 0.75±0.02cd | |
表4 番茄植株元素含量
Table 4 Mineral element contents in Solanum lycopersicum plants
处理 Treatment | 全氮 Total nitrogen (g/kg) | 全磷 Total phosphorus (g/kg) | 全钾 Total potassium (g/kg) | 全硫 Total sulfur (g/kg) | 全铁 Total iron (g/kg) | |
|---|---|---|---|---|---|---|
| CK1 | 37.33±0.99b | 8.20±0.28c | 60.27±1.69de | 11.26±0.22c | 0.48±0.04e | |
| CK2 | 35.90±1.47b | 7.80±0.38c | 58.47±3.27ef | 10.71±0.31de | 0.50±0.05e | |
| YNK-FB0053 | T1 | 35.90±0.62b | 9.20±0.29b | 63.50±1.90cd | 12.26±0.21b | 0.83±0.03b |
| T2 | 33.07±1.72c | 8.75±0.35b | 67.37±1.81b | 11.99±0.52b | 0.88±0.04b | |
| T3 | 35.17±0.64b | 9.79±0.09a | 73.43±0.83a | 13.34±0.20a | 0.78 ±0.01c | |
| YNK-FB0056 | T1 | 41.37±0.91a | 9.11±0.65b | 63.27±2.45cd | 11.32±0.16c | 0.73±0.10cd |
| T2 | 30.53±0.06d | 9.05±0.14b | 55.00±0.82f | 11.12±0.13cd | 0.77±0.02c | |
| T3 | 27.33±1.18e | 8.82±0.15b | 64.80±1.05bc | 11.47±0.16c | 0.70±0.03d | |
| YNK-FB0057 | T1 | 35.37±1.19b | 8.83±0.17b | 62.77±0.81cd | 10.45±0.33e | 0.84±0.03b |
| T2 | 42.40±1.35a | 8.96 ±0.21b | 66.63±1.56bc | 10.78±0.08de | 1.02±0.04a | |
| T3 | 26.27±1.81e | 9.83 ±0.16a | 64.80±3.77bc | 11.43±0.33c | 0.75±0.02cd | |

图11 菌株YNK-FB0053(A)、YNK-FB0056(B)和YNK-FB0057(C)的菌落形态及扫描电镜图
Fig. 11 Colony morphology and scanning electron microscope of strain YNK-FB0053(A), YNK-FB0056(B) and YNK-FB0057(C)

图12 菌株YNK-FB0053、YNK-FB0056和YNK-FB0057基于16S rRNA基因序列构建的系统发育树
Fig. 12 Phylogenetic tree of strain YNK-FB0053, YNK-FB0056 and YNK-FB0057 based on 16S rRNA gene sequences
| [1] | Supikova K, Kosinova A, Vavrusa M, et al. Sulfated phenolic acids in plants [J]. Planta, 2022, 255(6): 124. |
| [2] | Zenda T, Liu ST, Dong AY, et al. Revisiting sulphur—the once neglected nutrient: it’s roles in plant growth, metabolism, stress tolerance and crop production [J]. Agriculture, 2021, 11(7): 626. |
| [3] | Borpatragohain P, Rose TJ, Liu L, et al. Remobilization and fate of sulphur in mustard [J]. Ann Bot, 2019, 124(3): 471-480. |
| [4] | Chaudhary S, Dhanker R, Kumar R, et al. Importance of legumes and role of sulphur oxidizing bacteria for their production: a review [J]. Legume Res Int J, 2020: 275-284. |
| [5] | Shah SH, Islam S, Mohammad F. Sulphur as a dynamic mineral element for plants: a review [J]. J Soil Sci Plant Nutr, 2022, 22(2): 2118-2143. |
| [6] | Joshi N, Gothalwal R, Singh M, et al. Novel sulphur-oxidizing bacteria consummate sulphur deficiency in oil seed crop [J]. Arch Microbiol, 2021, 203(1): 1-6. |
| [7] | Jadhav SC, Salvi VG, Kasture MC, et al. Influence of different levels of sulphur and biofertilizers on soil properties and yield of mulched groundnut (Arachis hypogaea L.) in lateritic soils of Konkan region[J]. Pharma Innovation,2022, 11(1):1040-1045. |
| [8] | Li Q, Gao Y, Yang A. Sulfur homeostasis in plants[J]. International Journal of Molecular Sciences, 2020, 21(23): 8926. |
| [9] | Saha B, Saha S, Roy PD, et al. Microbial transformation of sulphur: an approach to combat the sulphur deficiencies in agricultural soils [M]//Role of Rhizospheric Microbes in Soil. Singapore: Springer Singapore, 2018: 77-97. |
| [10] | Santana MM, Dias T, Gonzalez JM, et al. Transformation of organic and inorganic sulfur-adding perspectives to new players in soil and rhizosphere [J]. Soil Biol Biochem, 2021, 160: 108306. |
| [11] | Zhao C, Wang J, Zang F, et al. Both water content and sulfur-oxidizing bacterial community affect elemental sulfur oxidation in soils with different textures[J]. Available at SSRN 4029206,2022. . |
| [12] | Das SK, Mishra AK, Tindall BJ, et al. Oxidation of Thiosulfate by a New Bacterium, Bosea thiooxidans. (strain BI-42) gen. nov., sp. nov.: Analysis of Phylogeny Based on Chemotaxonomy and 16S Ribosomal DNA Sequencing [J]. Int J Syst Bacteriol, 1996, 46(4): 981-987. |
| [13] | Nadella RK, Vaiyapuri M, Kusunur AB, et al. Isolation and characterization of sulphur oxidizing bacteria (Halothiobacillus sp.) from aquaculture farm soil [J]. J Environ Biol, 2019, 40(3): 363-369. |
| [14] | Shinde AH, Sharma A, Doshi S, et al. Isolation and screening of sulfur-oxidizing bacteria from coast of Bhavnagar, India, and formulation of consortium for bioremediation [J]. Environ Sci Pollut Res, 2022, 29(36): 54136-54149. |
| [15] | Xie ZZ, Li SR, Lin WT, et al. Parasulfuritortus cantonensis gen. nov., sp. nov., a microaerophilic sulfur-oxidizing bacterium isolated from freshwater sediment [J]. Int J Syst Evol Microbiol, 2021, 71(2): 004657. |
| [16] | Borse K, Agnihotri V, Bhandarkar H, et al. Effective sulfur oxidizing bacterial isolation from process waste water of food industry [J]. Plant Arch, 2021, 21(Suppliment-1): 1595-1604. |
| [17] | Chaudhary S, Dhanker R, Singh K, et al. Characterization of sulfur-oxidizing bacteria isolated from mustard (Brassica juncea L.) rhizosphere having the capability of improving sulfur and nitrogen uptake [J]. J Appl Microbiol, 2022, 133(5): 2814-2825. |
| [18] | Ashraf S. Isolation, screening and identification of lead and cadmium resistant sulfur oxidizing bacteria [J]. Pak J Agric Sci, 2018, 55(2): 349-359. |
| [19] | Sajjad W, Bhatti TM, Hasan F, et al. Characterization of sulfur-oxidizing bacteria isolated from acid mine drainage and black shale samples [J]. Pak J Bot, 2016, 48(3):1253-1262. |
| [20] | Chaudhary S, Dhanker R, Tanvi SG. Characterization and optimization of culture conditions for sulphur oxidizing bacteria after isolation from rhizospheric mustard soil, decomposing sites and pit house[J]. Int J Biol Biomol Agric Food Biotechnol Eng, 2017, 11:379-383. |
| [21] | 刘艳, 杨旭, 李加松, 等. 云南省油菜生产现状及发展建议 [J]. 中国农技推广, 2023, 39(10): 14-17. |
| Liu Y, Yang X, Li JS, et al. Present situation and development suggestions of rapeseed production in Yunnan Province [J]. China Agric Technol Ext, 2023, 39(10): 14-17. | |
| [22] | 国家统计局. 中国统计年鉴-2020 [M]. 北京:中国统计出版社,2020. |
| National Bureau of Statistics. China Statistical Yearbook-2020[M]. Beijing: China Statistics Press, 2020. | |
| [23] | 冯路遥, 赵江源, 施竹凤, 等. 森林根际土壤细菌的分离、鉴定及生物活性筛选 [J]. 生物技术通报, 2024, 40(1): 294-307. |
| Feng LY, Zhao JY, Shi ZF, et al. Isolation and identification of bacteria in forest rhizosphere soil and their biological activity screening [J]. Biotechnol Bull, 2024, 40(1): 294-307. | |
| [24] | Senthilkumar M, Amaresan N, Sankaranarayanan A. Quantitative estimation of sulfate produced by sulfur-oxidizing bacteria [M]//Plant-Microbe Interactions. New York, NY: Springer US, 2020: 73-75. |
| [25] | Joshi R, McSpadden Gardener BB. Identification and characterization of novel genetic markers associated with biological control activities in Bacillus subtilis [J]. Phytopathology® , 2006, 96(2): 145-154. |
| [26] | Mora I, Cabrefiga J, Montesinos E. Antimicrobial peptide genes in Bacillus strains from plant environments [J]. Int Microbiol, 2011, 14(4): 213-223. |
| [27] | 郑文艺, 韩海燕, 崔海超, 等. 欧洲疮痂链霉菌F5的鉴定及其抗菌活性 [J]. 微生物学通报, 2022, 49(6): 2111-2123. |
| Zheng WY, Han HY, Cui HC, et al. Characterization and antipathogenic activity of Streptomyces europaeiscabiei F5 from the rhizosphere of pigeon pea [J]. Microbiol China, 2022, 49(6): 2111-2123. | |
| [28] | 祁鹤兴, 赵映珺, 李鹏, 等. 产PK和NRP类抗生素苦豆子内生放线菌分子筛选及抗生素类型鉴定 [J]. 微生物学通报, 2016, 43(3): 583-592. |
| Qi HX, Zhao YJ, Li P, et al. Screening and identification of polyketide and non-ribosomal peptide antibiotics from endophytic actinomycetes of Sophora alopecuroides L [J]. Microbiol China, 2016, 43(3): 583-592. | |
| [29] | 布坎南. 伯杰细菌鉴定手册第八版 [M]. 8版. 北京: 科学出版社, 1984. |
| Buchanan RE. Bergey’s manual of determinative bacteriology [M]. 8th ed. Beijing: Science Press, 1984. | |
| [30] | 东秀珠, 蔡妙英. 常见细菌系统鉴定手册 [M]. 北京: 科学出版社, 2001. |
| Dong XZ, Cai MY. Handbook of identification of common bacterial systems [M]. Beijing: Science Press, 2001. | |
| [31] | Walsh PS, Metzger DA, Higuchi R. Chelex 100 as a medium for simple extraction of DNA for PCR-based typing from forensic material [J]. BioTechniques, 2013, 54(3): 134-139. |
| [32] | 廖永琴, 王楠, 申云鑫, 等. 三株酚酸降解菌的筛选与鉴定及其生物活性 [J]. 微生物学通报, 2024, 51(6): 2193-2214. |
| Liao YQ, Wang N, Shen YX, et al. Three phenolic acid-degrading bacterial strains: screening, identification, and biological activities [J]. Microbiol China, 2024, 51(6): 2193-2214. | |
| [33] | Vishnu, Sharma P, Kaur J, et al. Characterization of sulfur oxidizing bacteria and their effect on growth promotion of Brassica napus L [J]. J Basic Microbiol, 2024, 64(12): e2400239. |
| [34] | Maksimov IV, Singh BP, Cherepanova EA, et al. Prospects and applications of lipopeptide-producing bacteria for plant protection (review) [J]. Appl Biochem Microbiol, 2020, 56(1): 15-28. |
| [35] | Suárez-Moreno ZR, Caballero-Mellado J, Coutinho BG, et al. Common features of environmental and potentially beneficial plant-associated Burkholderia [J]. Microb Ecol, 2012, 63(2): 249-266. |
| [36] | Bhakat K, Chakraborty A, Islam E. Characterization of zinc solubilization potential of arsenic tolerant Burkholderia spp. isolated from rice rhizospheric soil [J]. World J Microbiol Biotechnol, 2021, 37(3): 39. |
| [37] | Zhang XC, Wang NN, Hou MM, et al. Contribution of K solubilising bacteria (Burkholderia sp.) promotes tea plant growth (Camellia sinesis) and leaf polyphenols content by improving soil available K level [J]. Funct Plant Biol, 2022, 49(3): 283-294. |
| [38] | Yang WT, Yi YJ, Xia B. Unveiling the duality of Pantoea dispersa: a mini review [J]. Sci Total Environ, 2023, 873: 162320. |
| [39] | 张德锋, 高艳侠, 王亚军, 等. 贝莱斯芽孢杆菌的分类、拮抗功能及其应用研究进展 [J]. 微生物学通报, 2020, 47(11): 3634-3649. |
| Zhang DF, Gao YX, Wang YJ, et al. Advances in taxonomy, antagonistic function and application of Bacillus velezensis [J]. Microbiol China, 2020, 47(11): 3634-3649. |
| [1] | 周江鸿, 夏菲, 仲丽, 仇兰芬, 李广, 刘倩, 张国锋, 邵金丽, 李娜, 车少臣. 黄栌枯萎病拮抗细菌CCBC3-3-1的全基因组测序及比较基因组分析[J]. 生物技术通报, 2024, 40(7): 235-246. |
| [2] | 靳海洋, 王慧, 张燕辉, 胡天龙, 林志斌, 刘本娟, 蔺兴武, 谢祖彬. 稻田土壤固氮菌株的分离筛选及促生潜力[J]. 生物技术通报, 2020, 36(6): 73-82. |
| [3] | 朱凤芝, 程赪, 刘祥胜, 张昆, 王立爽, 王敏, 骆健美. 利用响应面法优化巴卡亭III生成10-DAB的工艺条件[J]. 生物技术通报, 2017, 33(4): 238-246. |
| [4] | 赵明;. 微生物杀虫剂的研制[J]. , 1986, 0(12): 20-21. |
| [5] | 郝慧斌;. 合作研究微生物杀虫剂的协议[J]. , 1986, 0(02): 18-18. |
| 阅读次数 | ||||||
|
全文 |
|
|||||
|
摘要 |
|
|||||